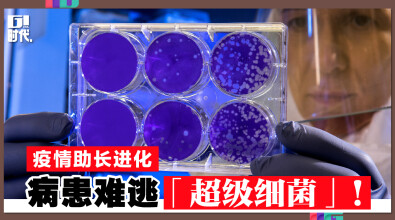
疫情助长进化 病患难逃「超级细菌」！

用Google搜寻老了吗?年轻人不太爱输入字!
你最常用的搜寻网站是哪一个呢?你是否知道,就连搜寻习惯也能暴露你属于那个世代?如果你还在使用Google,恐怕用的类别等于你是否跟得上时代了。
国华食品有限公司荣获马来西亚纪录大全 创 “2022年1月卖出最多南美白虾虾球” 辉煌纪录
国华食品有限公司今年五月荣获马来西亚纪录大全的“2022年1月卖出最多南美白虾虾球”的辉煌纪录,印证他们走对了路,在人生路上不断突破自我。
全球陷能源危机!泰国家庭改烧蜂窝煤
泰国家庭近来為省钱纷纷改烧蜂窝煤,虽受争议,但甚至连当地官员都相当支持此项节能政策。
Facebook 允合法分身 将可一人分饰五个身份
据报导,Meta 已开始测试让使用者拥有核心帐号以外,还能额外持有 4 个个人资料的作法。Meta 表示这些额外的 Profiles 不需要使用实名,目的是让使用者能切换不同目的对象。
二本清尘除蟎家居集团Urban Hygienist升級搬迁 创办人Esther Lim:秉持5信念 以人为本
二本清尘除蟎家居集团Urban Hygienist Sdn Bhd在槟城的自置办公大厦于7月11日举行隆重“升级搬迁、盛大开业”仪式,创办人兼总裁Esther Lim林美慧恭请OE杰青商学院董事长Dato (Dr)Calvin Khiu主持开幕典礼。
全球製造业存货 过量创最高纪录!
在通膨飙升拖累消费者需求之际,从三星到福特汽车,全球製造业第1季的存货总额冲上破纪录的1.8兆美元,令人忧心业者可能被迫减产,进而引发经济长期下滑。
美白手起家女富豪 致富祕訣:21岁当单亲妈
黛安‧韩卓克斯身价116亿元,连续五年摘下「富比世」杂志「美国白手起家女富豪」榜首;农家出生,早婚早离的韩卓克斯说,生养子女 ,「当妈的经验,让我快速成长」。
疫情助长进化 病患难逃「超级细菌」!
联邦疾病防治中心日前表示,新冠疫情大幅助长超级细菌感染的病例,死亡人数也激增,逆转了人类在现代公卫领域的进步。
E.L.Lim Dental Surgery Sri Petaling开幕志庆 Dr Elaine:坚持最贴心牙科保健!
E.L.Lim Dental Surgery开幕典礼,聚满人潮和祝贺花篮,舞狮在做着准备,天空还有无人摄影机在拍摄着盛况,场面很是热闹,嘉宾们盛装出席这家牙医诊所的开幕典礼。
陈赫收3.7亿退股贤合庄 遭疑「割韭菜」!
近日「陈赫退出福建贤合庄股东」引发热议,据悉,早前有多位贤合庄加盟商维权,喊话陈赫让多少家庭血本无归。
来学习「股神」巴菲特 度过熊市3大致胜法!
巴菲特的投资心法即便是新手也能效法。在股市遁入熊市之际,巴菲特度过熊市的三大法则可供投资人参考。
全球哪城市工作生活最平衡? 吉隆坡上“过度”榜
专注于远程安全系统的物联网公司Kisi,近期发布了2022年工作与生活平衡指数报告。该报告调查了美国的51个城市和世界其它地区的49个城市,根据工作强度、社会服务和城市宜居性,确定了这些城市工作与生活平衡的排名。
大马新车销量超越泰国 成东南亚第二大汽车市场
在大马几乎人均都拥有一辆车,但是实际上我们的新车销量却低于泰国,常年位居东南亚第二,不过在去年得益于大马新车销量大涨,让我们成功一举超越邻国泰国,成为了东盟区域内仅次于印尼的第二大汽车市场。
昔在乔布斯身边当实习生 今成为DataStax CEO
生成式AI企业DataStax的执行长卡普尔在刚进入科技业时,跟许多人一样从实习生干起,他当时被苹果公司创办人乔布斯看上,到他创立的NeXT软体公司担任实习生,而实习的经验,造就了他今天的成就。
“被叫亿万富豪是侮辱” 维珍创办人吐心声
富布斯估算英国维珍集团创办人布兰森的身家,在2024年高达25亿美元(约116亿令吉),外界常以“亿万富豪”称呼他,不过布兰森却认为,当有人只以“亿万富豪”描述他的话,他会感到相当侮辱。
通过给租房者“返点” 90后成为亿万富豪
在美国运通长期首席执行官的肯·切诺特的支持下,金融科技公司Bilt Rewards的90后创始人安库尔·贾恩,已经通过为全美各地的房屋和公寓租户创建会员奖励计划而成为了新晋亿万富豪。
57岁却像27岁 巴西帅气男分享冻龄秘诀
巴西网红布兰道过去17年靠着健康饮食和规律运动等方式,让他虽然已57岁但却常被误认为只有27岁,他说自己并没有害怕变老,只是想维持年轻,他在社群媒体分享自己的抗老秘诀,也公开他执行的包括充足睡眠、良好社交生活等10个冻龄秘方。